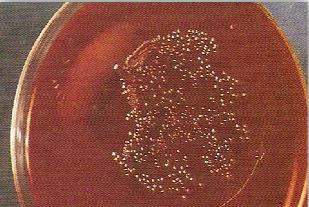
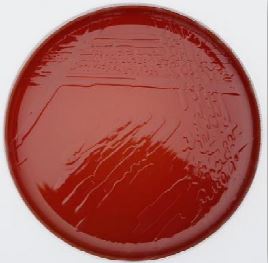
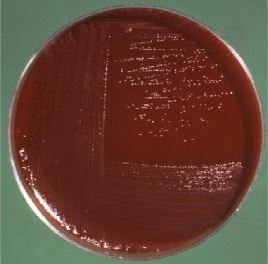
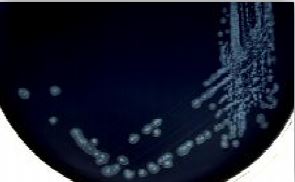

النبات

مواضيع عامة في علم النبات

الجذور - السيقان - الأوراق

النباتات الوعائية واللاوعائية

البذور (مغطاة البذور - عاريات البذور)

الطحالب

النباتات الطبية


الحيوان

مواضيع عامة في علم الحيوان

علم التشريح

التنوع الإحيائي

البايلوجيا الخلوية


الأحياء المجهرية

البكتيريا

الفطريات

الطفيليات

الفايروسات


علم الأمراض

الاورام

الامراض الوراثية

الامراض المناعية

الامراض المدارية

اضطرابات الدورة الدموية

مواضيع عامة في علم الامراض

الحشرات


التقانة الإحيائية

مواضيع عامة في التقانة الإحيائية


التقنية الحيوية المكروبية

التقنية الحيوية والميكروبات

الفعاليات الحيوية

وراثة الاحياء المجهرية

تصنيف الاحياء المجهرية

الاحياء المجهرية في الطبيعة

أيض الاجهاد

التقنية الحيوية والبيئة

التقنية الحيوية والطب

التقنية الحيوية والزراعة

التقنية الحيوية والصناعة

التقنية الحيوية والطاقة

البحار والطحالب الصغيرة

عزل البروتين

هندسة الجينات


التقنية الحياتية النانوية

مفاهيم التقنية الحيوية النانوية

التراكيب النانوية والمجاهر المستخدمة في رؤيتها

تصنيع وتخليق المواد النانوية

تطبيقات التقنية النانوية والحيوية النانوية

الرقائق والمتحسسات الحيوية

المصفوفات المجهرية وحاسوب الدنا

اللقاحات

البيئة والتلوث


علم الأجنة

اعضاء التكاثر وتشكل الاعراس

الاخصاب

التشطر

العصيبة وتشكل الجسيدات

تشكل اللواحق الجنينية

تكون المعيدة وظهور الطبقات الجنينية

مقدمة لعلم الاجنة


الأحياء الجزيئي

مواضيع عامة في الاحياء الجزيئي


علم وظائف الأعضاء


الغدد

مواضيع عامة في الغدد

الغدد الصم و هرموناتها

الجسم تحت السريري

الغدة النخامية

الغدة الكظرية

الغدة التناسلية

الغدة الدرقية والجار الدرقية

الغدة البنكرياسية

الغدة الصنوبرية

مواضيع عامة في علم وظائف الاعضاء

الخلية الحيوانية

الجهاز العصبي

أعضاء الحس

الجهاز العضلي

السوائل الجسمية

الجهاز الدوري والليمف

الجهاز التنفسي

الجهاز الهضمي

الجهاز البولي


المضادات الميكروبية

مواضيع عامة في المضادات الميكروبية

مضادات البكتيريا

مضادات الفطريات

مضادات الطفيليات

مضادات الفايروسات

علم الخلية

الوراثة

الأحياء العامة

المناعة

التحليلات المرضية

الكيمياء الحيوية

مواضيع متنوعة أخرى

الانزيمات
الجنس Campylobacter Spp
المؤلف:
عبد الرزاق سليمان التومي ، محمد محمد الامام ، عبد الباسط رمضان
المصدر:
اساسيات التشخيص البكتريولوجي المعملي والسريري
الجزء والصفحة:
14-7-2016
4702
Campylobacter Spp
هذا الجنس البكتيري شائع التواجد في الطبيعة ، حيث تم عزله من البيئات المائية المختلفة (مياه عذبة ومالحة) كما يتواجد بأعداد كبيرة في مياه الصرف الصحي وهو يتواجد بأعداد قليلة في المياه السطحية مقارنة بأعداد في مياه الصرف الصحي أما في المياه الجوفية فلهذا الجنس البكتيري القدرة على البقاء لعدة أسابيع عند درجة حرارة 4 درجات مئوية ويعتبر النوع البكتيري C. jejuni أكثرهم تواجداً في البيئات المائية مقارنة بالأنواع الأخرى من النوع البكتيري C. coli والنوع البكتيري C. lari. لا يعرف حتى الآن دور هذا الجنس البكتيري في احاديث الاصابات عند البشر كنتيجة لتواجدها في المياه نظراً لعدم معرفة طريقة انتقالها للإنسان وأيضاً لعدم توفر معلومات كافية حول مدى بقائها في مختلف البيئات ، حيث أظهرت بعض الدراسات قدرة هذا الجنس البكتيري على البقاء فقط لعدة ساعاة في الظروف البيئية غير الملائمة وذلك نتيجة لتغير درجات الحرارة، ومن خلال الدراسات المعملية تبين أنه قادر على البقاء لفترات طويلة في درجات الحرارة المنخفضة والتي قد تدوم لعدة أيام (4 درجات مئوية) كما أن تواجده يزداد في جود أجناس بكتيرية اخرى في الغشاء الحيوي biofilm ، كما أن بعض الأبحاث اظهرت ان للجنس البكتيري Campylobacter Spp القدرة على البقاء في البيئات المائية للفترات طويلة تتراوح من عدة أسابيع إلى عدة أشهر عند درجة حرارة أقل من 15 درجة مئوية ، كما تأكدك عدم وجوده في المياه المعالجة وإذا ماتم تحديد تواجده في المياه المعالجة بالكلور فهذا دليل على تلوث المياه بعد عملية التطهير أو لعدم كفاءة عملية المعالجة.
الامراضية :
يسبب النوع البكتيري C. jejuni والنوع البكتيري C. coli النزلات المعوية على هيئة إسهال مائي toxigenic watery diarrhea أو زحارdysentary ولهم القدرة على إفراز ذيفانات معوية enterotoxins واخرى مدمرة للخلايا cytotoxins . في الدول النامية يسبب هذين النوعين غالباً الإصابات في الأطفال الذين أعمارهم تقل عن عامين. ويتواجد هذا الجنس البكتيري في القانة الهضمية للدواجن والخراف والماعز والماشية والعديد من الحيوانات ، وبذلك يعتبر الدواجن والحليب غير المبستر وكذلك المياه الملوثة هم المصدر الرئيسي للإصابة ويعتقد أن المياه الجوفية الحيوانية حيث توفر طبقات الأرض السفلى الظروف البيئية الملائمة لنمو هذا الجنس البكتيري وبقائه ، ويزداد معدل انتشار الجانحات الناتجة من هذا الجنس البكتيري بمعدل تناول المياه الملوثة أو غير المعالجة، ففي بريطانيا يعتبر هذا الجنس البكتيري المصدر الرئيسي للحائجات الناتجة جراء تناول المياه الملوثة وغير المعالجة بطريقة جيدة ، كما يعتبر النوع البكتيري C. jejuni HS50 PT35 المسبب الرئيسي للجانحات الناتجة من استعمال إمدادات المياه الخاصة، وهي نادراً ما يتم عزلها. في كندا يعتبر النوع البكتيري Campylobacter Spp المسبب الرئيسي للنزلات المعوية وفي أغلب الدوال الأوربية تعتبر من الأجناس البكتيرية التي تلعب دوراً هاماً وأساسي في إحداث الإصابات عبر تناول المياه الملوثة ففي إحدى الجانحات التي ظهرت في السويد أصيب فيها أكثر من 6000 شخص ويقدر عدد المصابين بالنزلات المعوية بحوال 100-60 حالة لكل 100000 شخص في كل سنة، وفي بريطانيا تسجل أكثر من 550000 حالة إصابة بهذا الجنس البكتيري ، وفي أمريكا تسجل حوال 2.4 ملوين حالة سنويا ، إلا أنه وحتى الآن لم يحدد مدى تواجد هذا الجنس البكتيري في شبكات مياه الشرب.
مجموعة الجنس البكتيري Campylobacter Spp المقاومة للتهوية Arcobacter group of aerotolerant campylobacters : تسبب هذه المجموعة الإسهال، وهي لها القدرة على تحمل الهواء ولهذا سميت Aerobacter Spp ويمكن لهذه المجموعة النمو في درجات حرارة 15 ،25 و 36 درجة مئوية ولا يمكنها النمو في درجة حرارة 42 درجة مئوية . ولقد تم عزل النوع البكتيري A. butzleri من مرضى الإيدز وأطفال الدول النامية.
التشخيص المعملي :
شكلها عند الصبغ بصبغة basic fuchin % 1 يظهرها على هيئة لولبية او منحنية ، كما أن بعضها يكون على هيئة جناح النورس gull wings والبعض الآخر يكون على هيئة الحرف اللاتيني S أو واوية الشكل مما يعطي تشخيص إفتراض بإحتمال ان يكون هذا الجنس البكتيري هو المسبب للنزلة المعوية ، كما أنها سالبة لصبغة جرام (المستعمرات البكتيرية غير الجديدة تكون خلاياها على هيئة كريات وذلك نتيجة تعرضها للأوكسجين وهذه المستعمرات لا يمكن أن تنمو من جديد) يتراوح حجمها ما بين 0.4-0.2 ميكرومتر عرضاً و 5-0.5 ميكرومتر طولاً ، غير مكونة للأبواغ وهي بكتيريا متحركة بواسطة سوط يتواجد على احد أو كلا قطبي الخلية البكتيرية ما عدا النوع البكتيري C. gracilis فهو غير متحرك.

خلايا الجنس البكتيري Campylobacter Spp بصبغة جرام
يعتبر الجنس البكتيري Campylobacter Spp محب للهواء جزئياً 'Microaerophilic' فهو له القدرة على تحمل وجود نسبة قليلة من الأوكسجين ويحتاج عند نموه إلى حوال 5-3 % من غاز ثاني أكسيد الكربون وحوالي 15-3 % من غاز الأكسجين ، ودرجة الحرارة المفضلة حوالي 42 درجة مئوية . ويعتبر النوع البكتيري C. jejuni والنوع البكتيري C. coli من اهم انواع هذه البكتيريا ، وهي ممرضة للإنسان وتتواجد في مياه الشرب بالإضافة للنوع البكتيري C. upsaliensis وتصنف هذه المجموعة على أنها محبة للحرارة thermophilic. من الممكن عزل هذا الجنس البكتيري من عينة البراز باستعمال أحد الطرق التالية:
- طريقة الترشيح باستعمال وسط غذائي غير انتقائي: يتم ترشيح العينة من خلال مرشح بقطر 0.47 مم ذو مسامات بحجم 0.45 ميكرومتر مما يسمح بمرور الجنس البكتيري Campylobacter فقط.
1- يتم إضافة 1 جرام من عينة البراز لــ 10 مل من المحلول الملحي المعقم، مع المزج باستعمال خلاط (vortex mixer) لتكوين معلق بكتيري ، تم يترك في مكانة لمدة دقيقتين ليترسب ، أما إذا كانت عينة البزاز سائلة فلا ضرورة لإضافة المحلول الملحي.
2- يتم وضع المرشح على طبق يحتوي على الوسط الغذائي blood agar أو الوسط الغذائي chocolate agar ، بعد ذلك يتم وضع حوالي 10 قطرات من المعلق البكتيري على المرشح ، مع مراعات عدم تسرب هذه القطرات من حواف المرشح.
3- يترك المرشح بعد ذلك لمدة 60-30 دقيقة ثم ينزع.
4- يتم تحضين الطبق في 43-42 درجة مئوية، وفي ظروف قليلة التهوية، ولمدة 48 ساعة، ومن الممكن تحضينها في 37 درجة مئوية.
- استعمال الوسط الغذائي الانتقائي الذي يحتوي على المضادات الحيوية :
هناك العديد من الأوساط الغذائية التي يمكن أن تستعمل مع إضافة بعض المضادات الحيوية التي تمنع نمو الأجناس البكتيرية غير الممرضة مع إضافة مواد تساعد على النمو growth factors مثل :
ــ الوسط الغذائي Blaser's Medium وهو يحتوي على 10% من دم الخراف والمضاد الحيوي vancomycin والمضاد الحيوي trimethoprim والمضاد الحيوي polymyxin B والمضاد الحيوي cephalothin والمضاد الحيوي amphotericin B ويفضل استعمال الوسط الغذائي Brucella agar base ليضم هذه المكونات.
مستعمرات الجنس البكتيري Campylobacter Spp.نامية على الوسط الغذائيBrucella agar
ــ الوسط الغذائي Skirrow's blood agar : وهو يحتوي على دم حصان محلل والمضاد الحيوي polymyxin B والمضاد الحيوي trimethoprim ويتم ذلك باستعمال الوسط الغذائي blood agar base (No.2 Oxoid)
الجنس البكتيري Campylobacter على الوسط الغذائي Skirrow's blood agar
تظهر مستعمرات النوع البكتيري C. jejuni والنوع البكتيري C. coli نمو خال من إحلال لكريات الدم الحمراء.
ــ الوسط الغذائي Butzler virion medium : وهو يحتوي على دم خراف منزوع الفيبرين defibrinated sheep blood ، والمضاد الحيوي Cefoperazone والمضاد الحيوي rifampicin والمضاد الحيوي colistin والمضاد الحيوي amphotericin B وباستعمال الوسط الغذائي Columbia agar base.
النوع البكتيري Campylobacter jejuni على الوسط الغذائي Butzler virion agar
ــ الوسط الغذائي Improved preston free medium : وهو يحتوي على المضاد الحيوي cefoperazone والمضاد الحيوي amphotericin مع الوسط الغذائي Campylobacter blood free agar base وهو يحتوي على الفحم النباتي charcoalو ferrous sulphate و sodium deoxycholate و sodium pyruvate و casein hydrilysate مع nutrient broth and agar ، هذا الوسط الغذائي يساعد على نمو الجنس البكتيري . Campylobacter Spp عند تحضينه في درجة حرارة 37 درجة مئوية بدلاً من درجة الحرارة 43-42 درجة مئوية . وينصح بعض البحاث بتحضين العينة في درجة حرارة 37 درجة مئوية لمدة 24 ساعة ثم تحضينها من جديد في درجة حرارة 42 درجة مئوية لمدة 24 ساعة. ويرى بعض البحاث أنه الوسط الغذائي الأفضل لنمو وعزل النوع البكتيري C. jejuni.
يكون لون مستعمرات النوع البكتيري C. jejuni رمادية مسطحة، بعض المستعمرات النامية تظهر لوناً مخضراً وتبدو جافة المظهر. اما النوع البكتيري C. coli غالباً ما يظهر مستعمرات رمادية منتفخة بعض الشيء.
الجنس البكتيري campylobacter Spp على الوسط الغذائي Blood free medium
الاختبارات المعملية :
ــ اختبار الكشف على انزيم oxidase : موجب.
ــ اختبار الكشف على انزيم catalase : موجب .
ــ اختبار الكشف على انزيم urease : سالب
وهم أهم الاختبارات الافتراضية لتشخصية حالات النزلة المعوية الناتجة من الإصابة بالجنس بالكتيري . Campylobacter Spp
ــ اختبار الكشف على تحلل الهيبورايت Hippurate hydrolysis : وهو يستعمل للتفريق بين النوع البكتيري C. jejuni (موجب) والنوع البكتيري c. coli (سالب).
 الاكثر قراءة في البكتيريا
الاكثر قراءة في البكتيريا
 اخر الاخبار
اخر الاخبار
اخبار العتبة العباسية المقدسة

الآخبار الصحية















 قسم الشؤون الفكرية يصدر كتاباً يوثق تاريخ السدانة في العتبة العباسية المقدسة
قسم الشؤون الفكرية يصدر كتاباً يوثق تاريخ السدانة في العتبة العباسية المقدسة "المهمة".. إصدار قصصي يوثّق القصص الفائزة في مسابقة فتوى الدفاع المقدسة للقصة القصيرة
"المهمة".. إصدار قصصي يوثّق القصص الفائزة في مسابقة فتوى الدفاع المقدسة للقصة القصيرة (نوافذ).. إصدار أدبي يوثق القصص الفائزة في مسابقة الإمام العسكري (عليه السلام)
(نوافذ).. إصدار أدبي يوثق القصص الفائزة في مسابقة الإمام العسكري (عليه السلام)


















